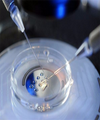

上海找个正规代孕医院,男方患有少精弱精症可以做试管婴儿吗?_上海私立医院
发布日期:2024-09-23
点赞量:509



上海试管助孕中心 上海冻卵费用 ‘酒精测男女要怀孕几周’
发布日期:2025-12-05
点赞量:154





上海代怀孕生男孩,北京供卵试管费用机构,真花不了10万-上海供卵试管公司有
发布日期:2024-09-10
点赞量:371
友情链接:
西安代怀生子

